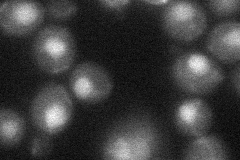
YDR291W
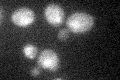
YDR291W

View description
Putative RecQ helicase; belongs to the widely conserved RecQ family of proteins which are involved in maintaining genomic integrity; similar to the human RecQ4p implicated in Rothmund-Thomson syndrome(RTS)
Localization:
Intensity:
Fold change:
Significance:
-
C’ GFP library in SD

nucleus19.27 -
N' NOP1pr-GFP in SD

nucleus69.836 -
N' TEF2pr-mCherry in SD

nucleus73.2509 -
N' NATIVEpr-GFP in SD

nucleus24.4771 -
N' TEF2pr-VC and Cyto-VN in SD
nucleus34.0325 -
C’ GFP library in SD+DTT

nucleus18.530.96No -
C’ GFP library in SD+H2O2
nucleus23.331.21No -
C’ GFP library in Starvation Media

nucleus19.461.01No -
C’ GFP library on the background of Pup2-DaMP

nucleus -
C’ GFP library on the background of CCT mutant

nucleus26.1031.35414No
